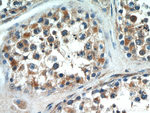
C20orf19 Antibody in Immunohistochemistry (Paraffin) (IHC (P))

Search
Proteintech
C20orf19 Polyclonal Antibody
{{$productOrderCtrl.translations['antibody.pdp.commerceCard.promotion.promotions']}}
{{$productOrderCtrl.translations['antibody.pdp.commerceCard.promotion.viewpromo']}}
{{$productOrderCtrl.translations['antibody.pdp.commerceCard.promotion.promocode']}}: {{promo.promoCode}} {{promo.promoTitle}} {{promo.promoDescription}}. {{$productOrderCtrl.translations['antibody.pdp.commerceCard.promotion.learnmore']}}
产品信息
21177-1-AP
种属反应
宿主/亚型
分类
类型
抗原
偶联物
形式
浓度
纯化类型
保存液
内含物
保存条件
运输条件
产品详细信息
Immunogen sequence: PVSEYCESE NKWSQEKHSP WEGVSDHLAH REPKSQKPFR KMQEEEEESW STSSDLTISI SEDDLILESP EPQPNPGGKM EGEDGIEALK LIHAEQERVA LSTEKNCILQ TLSSPDSEKE SSTNAPTREP GQTPDSDVPR AQVGQHVATL KEHDNSVKEE ATALLRKALT EECGRRSAIH SSESSCSLPS ILNDNSGIKE AKPAVWLNSV PTREQEVSSG CGDKSKKENV AADIPITETE AYQLLKKATL QDNTNQTENR FQKTDASVSH LSGLNIGSGA FETKTANKIA SEASFSSSEG SPLSRHENKK KPVINLKSNA LWDESDDSNS EIEAALRPRN HNTDDSDDFY D (324-673 aa encoded by BC045826)
靶标信息
Centrosomal protein required for establishing a robust mitotic centrosome architecture that can endure the forces that converge on the centrosomes during spindle formation. Required for stabilizing the expanded pericentriolar material around the centriole.
仅用于科研。不用于诊断过程。未经明确授权不得转售。
生物信息学
蛋白别名: Centrosomal protein kizuna; Polo-like kinase 1 substrate 1
基因别名: C20orf19; HT013; KIZ; Kizuna; NCRNA00153; PLK1S1; RP69
UniProt ID: (Human) Q2M2Z5
Entrez Gene ID: (Human) 55857